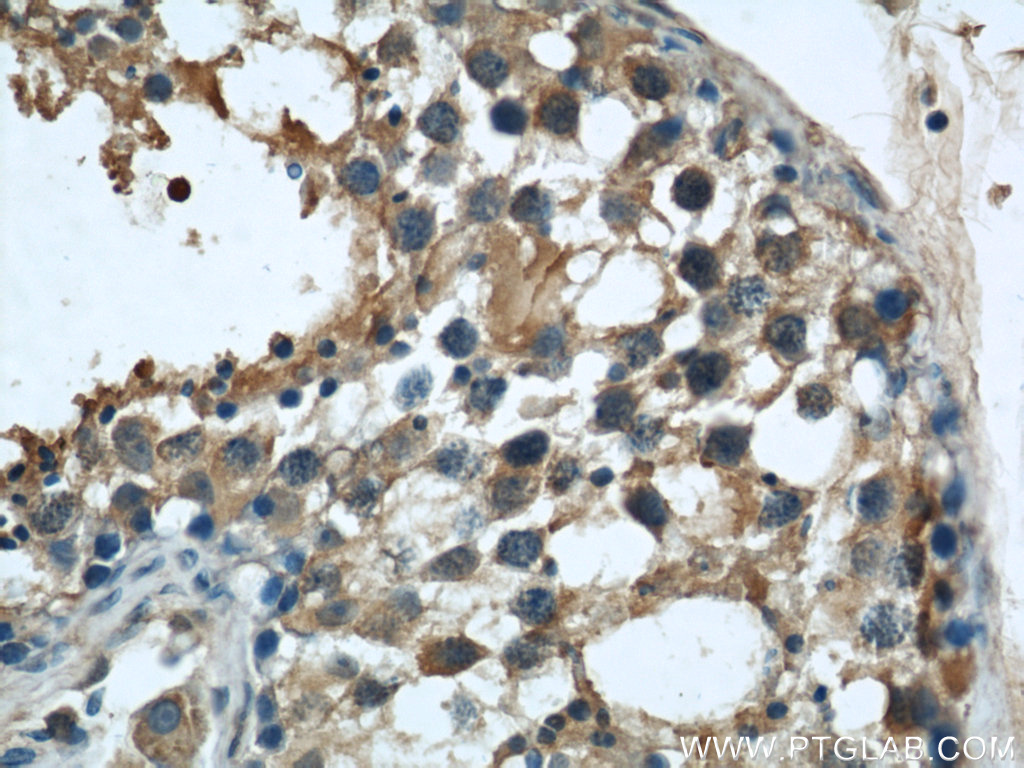

验证数据展示
经过测试的应用
| Positive WB detected in | fetal human brain tissue, MCF-7 cells, HeLa cells, ROS1728 cells, RAW 264.7 cells, zebrafish tissue |
| Positive IHC detected in | human kidney tissue, human testis tissue Note: suggested antigen retrieval with TE buffer pH 9.0; (*) Alternatively, antigen retrieval may be performed with citrate buffer pH 6.0 |
| Positive IF/ICC detected in | MCF-7 cells |
推荐稀释比
| 应用 | 推荐稀释比 |
|---|---|
| Western Blot (WB) | WB : 1:2000-1:16000 |
| Immunohistochemistry (IHC) | IHC : 1:20-1:200 |
| Immunofluorescence (IF)/ICC | IF/ICC : 1:50-1:500 |
| It is recommended that this reagent should be titrated in each testing system to obtain optimal results. | |
| Sample-dependent, Check data in validation data gallery. | |
发表文章中的应用
| WB | See 3 publications below |
| CoIP | See 1 publications below |
产品信息
66082-1-Ig targets CISD2-Specific in WB, IHC, IF/ICC, CoIP, ELISA applications and shows reactivity with human, zebrafish, rat, mouse samples.
| 经测试应用 | WB, IHC, IF/ICC, ELISA Application Description |
| 文献引用应用 | WB, CoIP |
| 经测试反应性 | human, zebrafish, rat, mouse |
| 文献引用反应性 | human, mouse |
| 免疫原 |
Fusion Protein 种属同源性预测 |
| 宿主/亚型 | Mouse / IgG2b |
| 抗体类别 | Monoclonal |
| 产品类型 | Antibody |
| 全称 | CDGSH iron sulfur domain 2 |
| 别名 | CDGSH iron sulfur domain 2, CDGSH2, CISD2, CISD2-Specific, ERIS, Miner1, MitoNEET related 1 protein, NAF 1, WFS2, ZCD2 |
| 观测分子量 | 15 kDa |
| GenBank蛋白编号 | NM_001008388 |
| 基因名称 | CISD2 |
| Gene ID (NCBI) | 493856 |
| RRID | AB_11232425 |
| 偶联类型 | Unconjugated |
| 形式 | Liquid |
| 纯化方式 | Protein A purification |
| UNIPROT ID | Q8N5K1 |
| 储存缓冲液 | PBS with 0.02% sodium azide and 50% glycerol, pH 7.3. |
| 储存条件 | Store at -20°C. Stable for one year after shipment. Aliquoting is unnecessary for -20oC storage. |
背景介绍
CISD2 gene encodes a 15 kDa CDGSH iron-sulfur domain-containing protein 2, which is also named Miner1 or NAF-1, this protein was reported on endoplasmic reticulum membrane or mitochondrion outer membrane. Defects in CISD2 are the cause of Wolfram syndrome type 2 (WFS2), a rare disorder characterized by juvenile-onset insulin-dependent diabetes mellitus with optic atrophy. CISD2 regulates autophagy program by interacting BCL2, contributing to antagonize BECN1-mediated cellular autophagy at the endoplasmic reticulum. This monoclonal antibody is specific to CISD2 and does not cross-react with CISD1.
实验方案
| Product Specific Protocols | |
|---|---|
| IF protocol for CISD2-Specific antibody 66082-1-Ig | Download protocol |
| IHC protocol for CISD2-Specific antibody 66082-1-Ig | Download protocol |
| WB protocol for CISD2-Specific antibody 66082-1-Ig | Download protocol |
| Standard Protocols | |
|---|---|
| Click here to view our Standard Protocols |
发表文章
| Species | Application | Title |
|---|---|---|
Commun Biol Integrating apaQTL and eQTL analysis identifies a potential causal variant associated with lung adenocarcinoma risk in the Chinese population | ||
J Biomed Sci Extracellular arginine availability modulates eIF2α O-GlcNAcylation and heme oxygenase 1 translation for cellular homeostasis | ||
Mol Neurodegener Mitochondrial CISD1/Cisd accumulation blocks mitophagy and genetic or pharmacological inhibition rescues neurodegenerative phenotypes in Pink1/parkin models | ||
Nat Commun ER calcium depletion as a key driver for impaired ER-to-mitochondria calcium transfer and mitochondrial dysfunction in Wolfram syndrome |